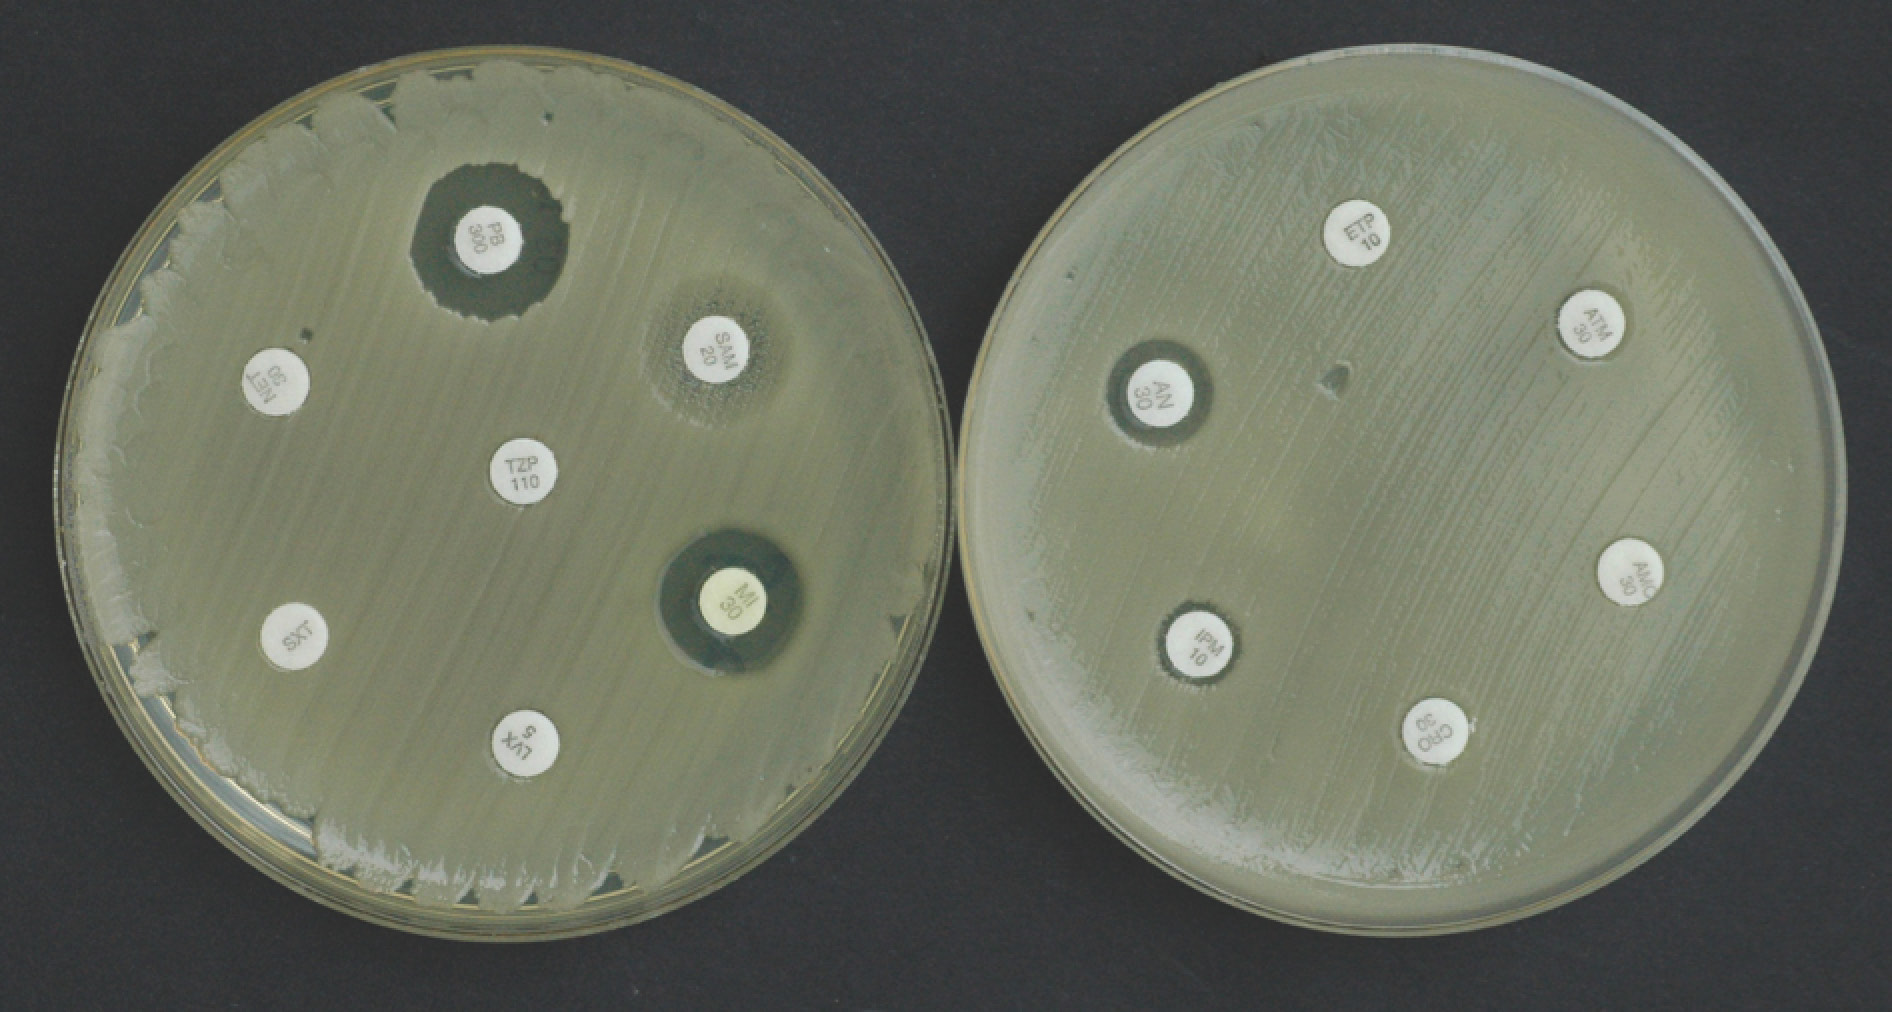

Clinical Vignette 15 (Technical)
This is a more “specialised” and technical clinical vignette.
An elderly man was admitted to the intensive care unit (ICU) for acute respiratory distress from pulmonary oedema, and required intubation with mechanical ventilation. He had multiple co-morbid conditions including diabetes mellitus, hypertension, hyperlipidaemia, and ischaemic heart disease (with left ventricular ejection fraction of 35%). Three days into his ICU stay, he spiked a fever of 38.3 degrees Celsius, with high white cell count and serum procalcitonin of 3.2 ng/ml. His chest X-ray showed new right middle and lower zone infiltrates and he was prescribed intravenous (IV) meropenem for presumptive ventilator-associated pneumonia (VAP).
Two days later, his fever remained unchecked and his ventilatory requirements had increased. His blood and lower respiratory cultures were positive for Acinetobacter baumannii, which was resistant to all antibiotics except polymyxins and minocycline. The figure below shows the susceptibility test results by disk diffusion (courtesy of A/Prof Koh Tse Hsien of SGH).
Question: What antibiotic(s) would you treat his VAP and nosocomial bacteraemia?
[Updated 10th January 2015]
This is one of the controversial areas in infectious diseases now, and also one where there is a pressing need for more and better evidence to guide clinical decision making. The issue is whether polymyxin monotherapy is sufficient, or combination antibiotic therapy (using one or even two more antibiotics in combination with polymyxin) will deliver a better clinical outcome for the patient infected with such extensively drug-resistant (XDR) bacteria. The polymyxins (polymyxin B and colistin, which is polymyxin E) are currently “last-line” antibiotics against XDR-Gram negative bacteria. The trouble is that compared with antibiotics like the beta-lactams (i.e. penicillins, cephalosporins and carbapenems), they are far less effective and are also more toxic. Developed in the 1960s, physicians stopped using them after cephalosporins and carbapenems entered the market, only to re-adopt them because of the mounting problem of Gram-negative antimicrobial resistance.
In vitro studies appear to demonstrate synergistic activity between polymyxin and other antibiotics, especially rifampicin (the anti-tuberculosis drug) and the carbapenems. However, these effects do not extend to all members of the targeted bacterial species (usually Pseudomonas aeruginosa and Acinetobacter baumannii are tested, as these are currently the bacteria with the most drug-resistant members), and it has been understood for a long time that in vitro results often correlate poorly with in vivo outcomes. The addition of another one or two antibiotics also has its downsides: besides the obvious increase in costs for the patient (or insurance), there is also the increased risk of developing adverse reactions to the treatment, and increased “collateral damage” in the form of antibiotic selection pressure on patient and environmental microflora.
One large scale multi-centre randomised open label clinical trial published recently failed to demonstrate the superiority of colistin and rifampicin when compared against colistin alone for the treatment of severe XDR-A. baumannii infections. Although the bacteria were cleared more rapidly from the patients, there was no reduction in the proportion of patients that died in each of the treatment arms. There are other ongoing trials comparing polymyxins and carbapenems against polymyxins alone, such as the one listed here. But I am personally not optimistic about the outcomes.
Therefore at this point in time, it is unclear whether monotherapy (with polymyxins) or combination therapy (polymyxins and another drug) would better benefit our case patient, and what such a patient will receive in terms of antimicrobial therapy becomes subject to physician preference. Ideally, the choice of therapy and outcomes should be recorded down in a database for future compilation and assessment, even while we await the outcomes of the ongoing clinical trials.
There is one further issue in the treatment of XDR-Gram-negative VAP where polymyxins are the only drugs that the bacteria are susceptible to, and that is whether nebulized (i.e. aerosolised) colistin should be used – either alone or in combination with intravenous polymyxins. Systemic (i.e. intravenous) polymyxins appear to penetrate the alveolar lining and lung parenchyma poorly, and delivery of colistin directly to the lung via the respiratory route results in better outcomes for experimental animal models of pneumonia when compared to intravenous colistin alone. Many case reports also suggest that nebulized colistin may be potentially efficacious, although a clear benefit has not been shown in larger clinical studies.